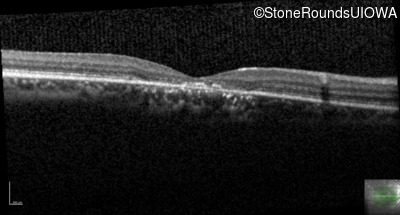
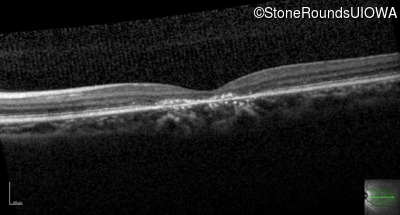
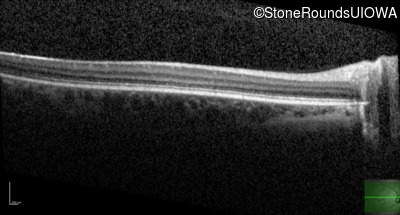
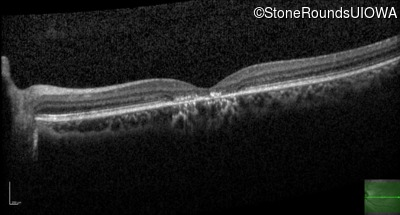
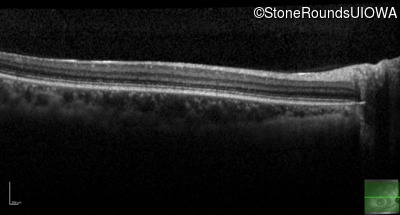
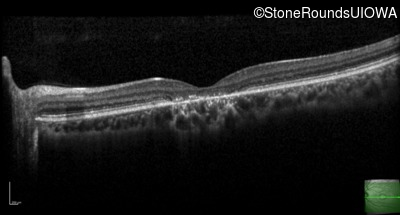
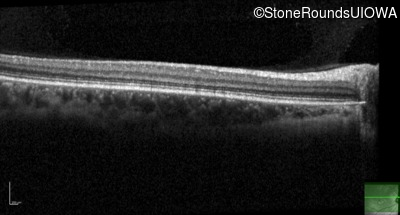
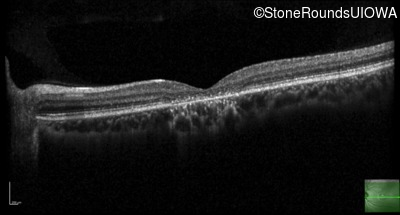

Case
SR504
Student Mode
AR Stargardt Disease (IIA)
Male
Male
Hidden
SR504
Student Mode
AR Stargardt Disease (IIA)
Male
Male
| Age at visit: 14 years |
| Age at visit: 15 years |
| Age at visit: 16 years |
Diagnosis & molecular findings
| Disease | Gene | Allele 1 variant(s) | Allele 2 variant(s) | Inheritance mode |
|---|---|---|---|---|
| AR Stargardt Disease | ABCA4 | Gly1961Glu GGA>GAA | Asp1613 del1gA | AR |
Disease:
Gene:
Allele 1:
Gly1961Glu GGA>GAA
Allele 2:
Asp1613 del1gA
Inheritance:
AR